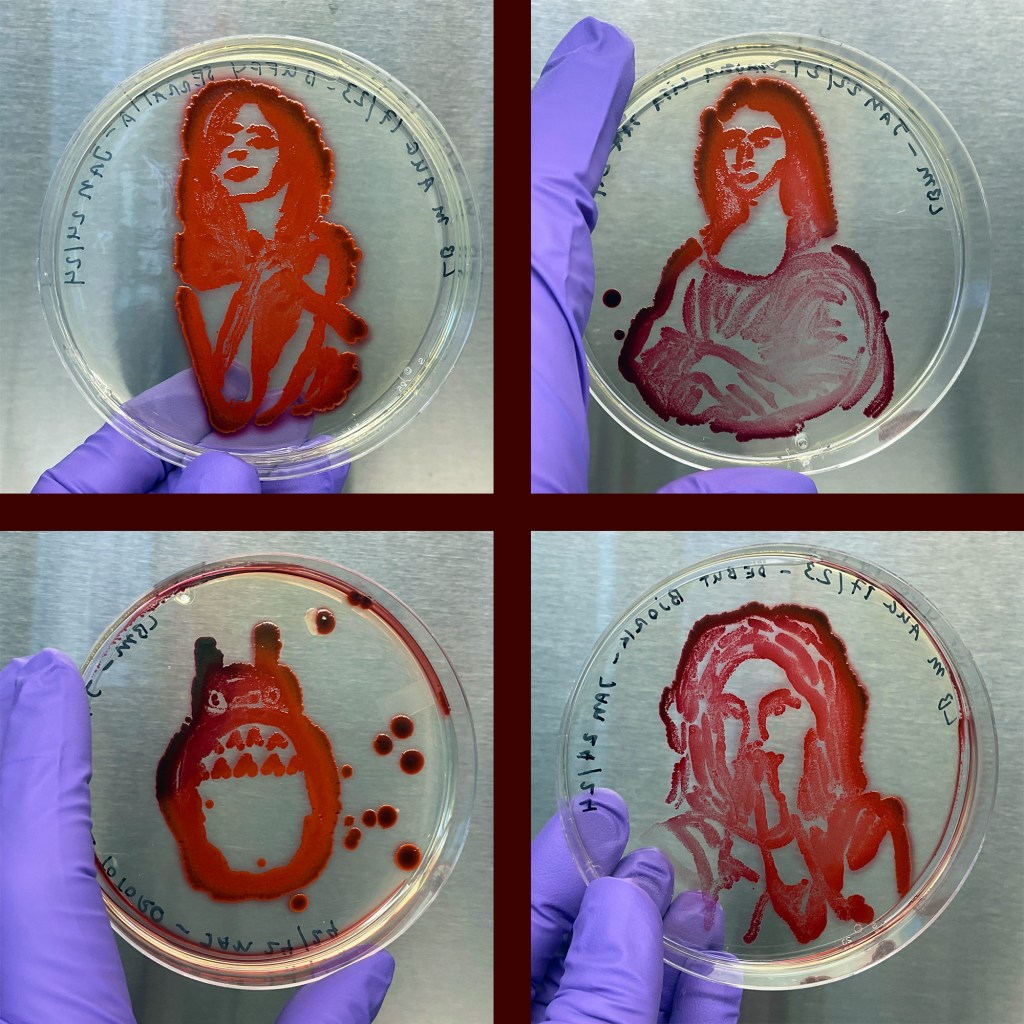
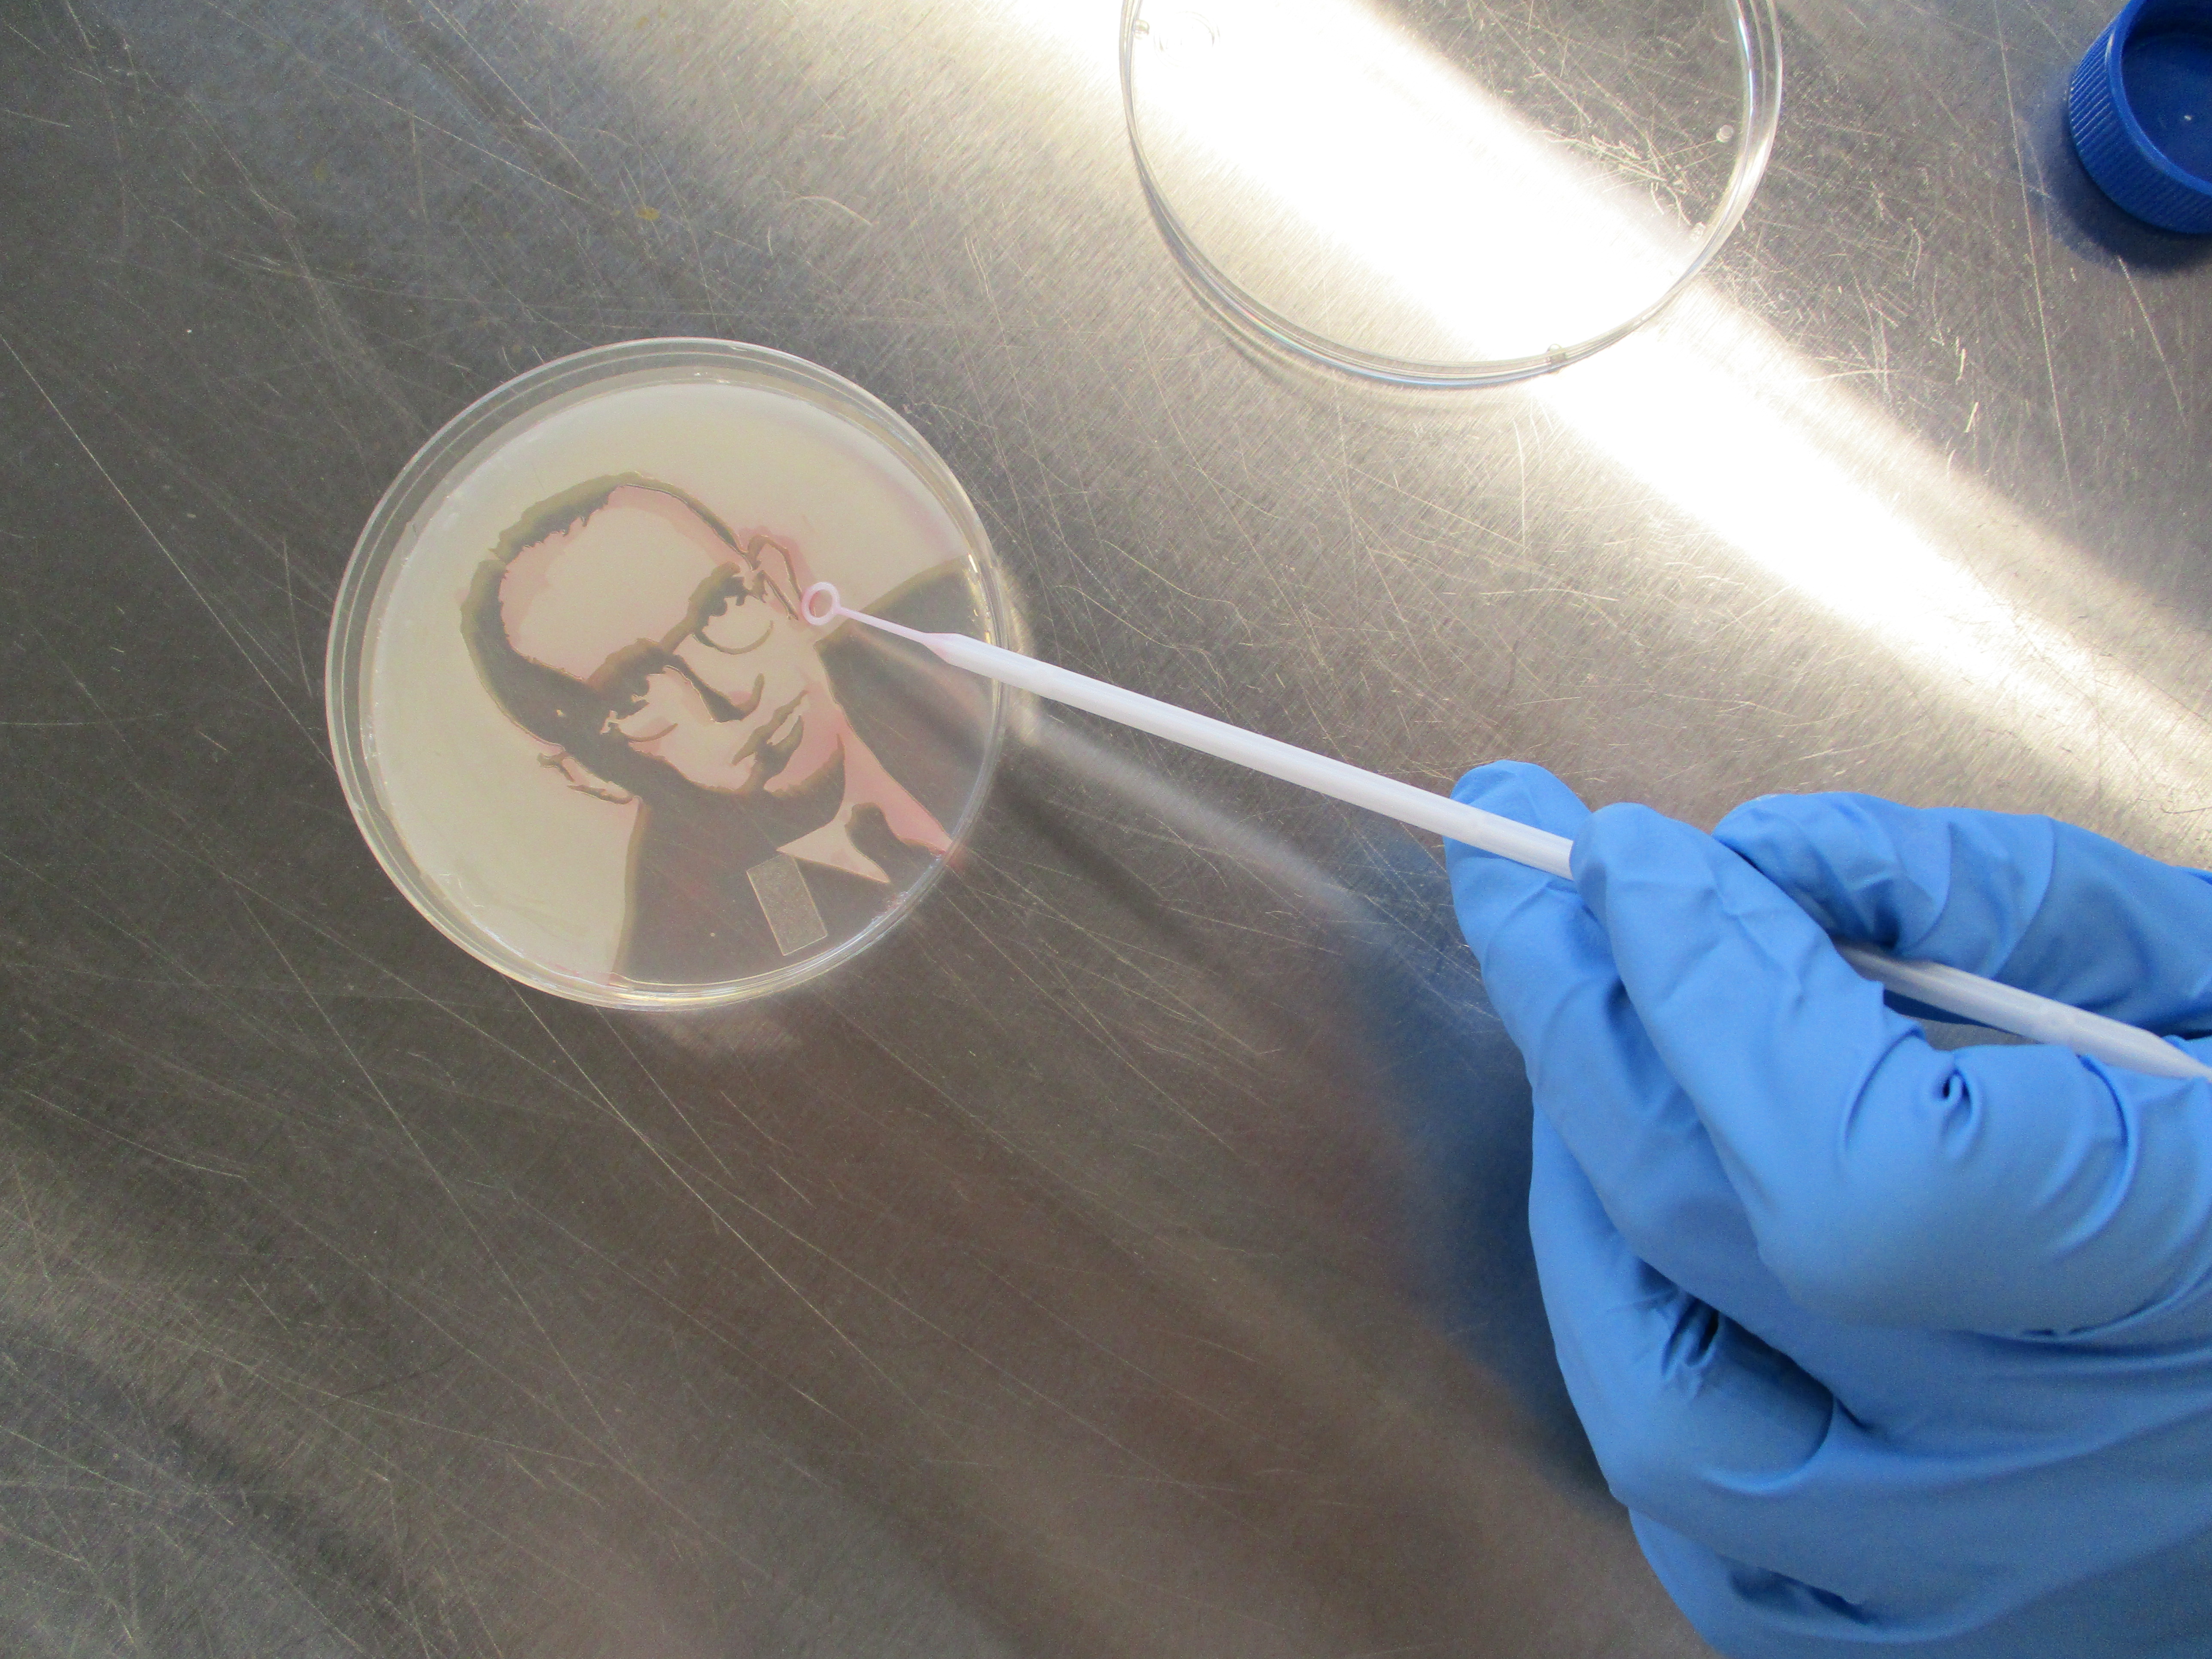

2024 Workshop season is upon us.
The first session, ‘Bacterial Portraiture,’ is Friday, February 2nd 2024 from 1:00 – 4:00 pm.
Come explore the microbiome & create small-scale portraits with bacteria!
This introductory workshop explores the use of bacteria as a creative—living—medium. We will focus on two different portraiture techniques and participants will learn the basics of sterile technique and other introductory lab skills such as how to prepare petri dishes and liquid media.

Reserve a space as slots are limited. Contact marc.beaulieu@concordia.ca, and be sure to include ‘Bacterial Portraiture’ in the subject line.
***WORKSHOP IS FULL***
